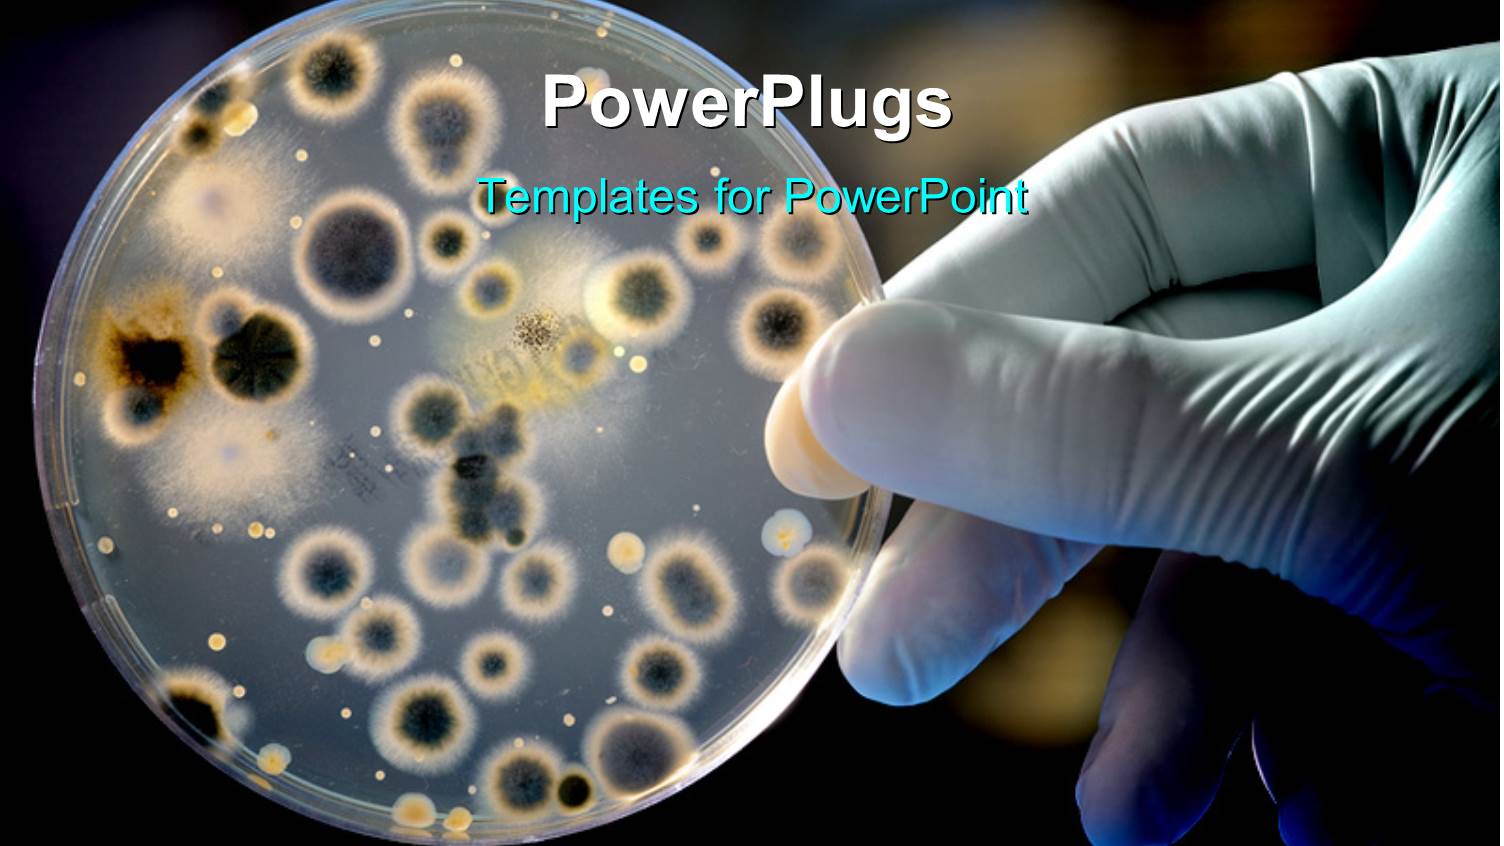
Hands in Surgical Glove Holding Petri Dish with Bacteria Culture

We’ve got the templates you’re looking for.
Millions of PowerPoint templates. High resolution backgrounds. Your choice of designs. Downloadable. Affordable. Compatible. Satisfaction guaranteed. From an award-winning leader in presentation graphics.
From $19

We have over 6 million CrystalGraphics brand presentation templates ready for you now.
Featuring high-resolution (4k) background images and videos.

Revealing an amazing level of detail.

With your choice of customizable designs and slide formats.

And 64+ unique slide layouts per template to give you more flexibility to tell your story.




Choose any Option Below for Instant Access
Millions of Presentation Templates. Award-Winning Designs. Affordable Purchasing Options.
What's included:
- This designer template includes 4 versions, each with 9 layouts.
- 2 versions are widescreen and the other 2 have standard size slides.
- Each size template comes in 2 artistically unique versions.
- PowerPoint (PC & Mac) compatible
- Google Slides compatible
- 30-day satisfaction guarantee
MOST POPULAR
Templates Subscription (1 year)



(List price: $129)
$99
★★★★★
What's included:
- An unlimited number of trial version templates for presentations
- Plus, every day download up to 25 premium quality (PowerPlugs-brand) With a subscription, PowerPlugs templates are easy to download. Just sign in, find a template and click on the green Download button. designer templates for presentations, with over 32,000 to choose from
- Plus, during the year, download
your choice of 50 premium quality (Crystal-brand) Crystal brand templates are our line of templates that have customization options. They have the word "CRYSTAL" on their web page images. You can customize several aspects of the templates. customizable templates for presentations,
with over 6 million to choose from - PowerPoint (PC & Mac) compatible
- Google Slides compatible
- 30-day satisfaction guarantee
BEST VALUE
The Ultimate Combo

(List price: $366)
$149
★★★★★
What's included:
- An unlimited number of trial version templates for presentations
- Plus, every day during the year, you can download up to 25 premium quality (PowerPlugs-brand) With a subscription, PowerPlugs templates are easy to download. Just sign in, find a template and click on the green Download button. designer templates for presentations, with over 32,000 to choose from
- Plus, during the year, download
your choice of 50 premium quality (Crystal-brand) Crystal brand templates are our line of templates that have customization options. They have the word "CRYSTAL" on their web page images. You can customize several aspects of the templates. customizable templates for presentations,
with over 6 million to choose from - Also includes over 2,000 designer chart and diagram slides to illustrate key concepts in your presentations
- And 300 animated 3D character slides to make your presentations more fun
- And a PC plugin to easily add quizzes to get your audiences involved
- 30-day satisfaction guarantee
PowerPoint Templates FAQs
Please review these FAQs to see if your question is answered. Contact us for more info
-
- A well designed PowerPoint template is a file that can tell PowerPoint how to make your ordinary templates look extraordinary. They won’t change what your words or numbers say. But they might change their size, color, font and placement. And, overall, they can give your presentations a professionally-designed look that will give your content more credibility and give you more confidence.
-
- We have over 32,000 artist-created presentation templates in our PowerPlugs collection With a subscription, PowerPlugs templates are easy to download. Just sign in, find a template and click on the green Download button. ready for you to download. That alone offers you more variety to choose from than any of our competitors can offer. And, as if that weren’t enough, we also offer over 6 million templates in our Crystal collection. Crystal brand templates are our line of templates that have customization options. They have the word "CRYSTAL" on their web page images. You can customize several aspects of the templates. These templates include high-resolution background images from Shutterstock’s vast image collection matched up with artist-created presentation designs customized by our own proprietary AI software.
-
- You can download an unlimited number of PowerPlugs-brand With a subscription, PowerPlugs templates are easy to download. Just sign in, find a template and click on the green Download button. templates every day for an entire year. (Actually, by default, we set a limit of 25 templates per day to prevent our competitors from stealing our templates. But, if that is not enough, just let us know and we’ll try to accommodate you.) On top of that, with a subscription or an Ultimate Combo, you can also download any 50 Crystal-brand Crystal brand templates are our line of templates that have customization options. They have the word "CRYSTAL" on their web page images. You can customize several aspects of the templates. templates per year selected from our huge Crystal collection. Crystal brand templates are our line of templates that have customization options. They have the word "CRYSTAL" on their web page images. You can customize several aspects of the templates. .
-
- We’ve got a larger selection of professionally-designed PowerPoint templates than anyone else in the world.
- Each template includes a high-resolution background image or video to visually inspire your audiences while reinforcing your message.
- Each template includes 64 slide layouts to give you maximum flexibility as you create your presentations.
- Our templates are available in both standard and widescreen slide formats. And our website lets you preview the slides each way.
- Our free Template Finder™ plugin lets subscribers select and - with a single click - download and insert our templates into their presentations right from within PowerPoint.
- We’ve been creating designer presentation templates for over 20 years. During that time we’ve won several awards and 5-star ratings for product quality. See About Us for more.
-
- Yes we do! We offer full 30-day money-back guarantee if you are not 100% satisfied with your purchase.
-
- Yes. After your subscription expires, you won't lose any rights or ability to use your PowerPlugs: Templates for PowerPoint. You won't be able to download any new non-watermarked templates. But the non-watermarked templates you've already downloaded will still work and you can still use them as before.
-
- Sorry but no. You are authorized to download each paid-for template to up to 3 of your personal devices and to use the templates you download in as many presentations as you want. But you are not authorized to share the templates, themselves, with others. That said, we do offer highly discounted site licenses to suit the needs of both small and large teams. Just tell us your needs and we’ll give you a quote!
-
- The templates use the standard POTX format. So they are compatible with Google Slides and all PC, Mac and mobile devices running any version of PowerPoint from PowerPoint 2007 up through and including Office 365 desktop.
- Please note: Google Slides does not currently support background videos. It treats them as still images.
- For PowerPoint for the Web, first open your template into a desktop version of PowerPoint, then save it back out as a PPTX file. Then you can open that in PowerPoint for the Web.
More FAQs
-
- You may download your selected templates as soon as your payment is received by PayPal. If you purchased an individual template, you will be provided with a download link both onscreen and via email. Just click on that link to begin the download process. If you purchased a subscription, you will receive an email containing a password to use along with your email address to sign in to any of the templates pages on CrystalGraphics.com. Once you are signed in, you can immediately start downloading your selected templates.
-
- You can either open a template to start a new presentation or you can add a template to an existing presentation. To open a template, just double click on it or use PowerPoint's File > Open tool. To add a template to an existing presentation, on the Design tab, in the Themes group, click Browse for Themes... then browse to select your template.
To learn about educational or volume discounts, or if you have any other questions,
please email us using this online form. One of our helpful sales associates will be glad to assist you.



